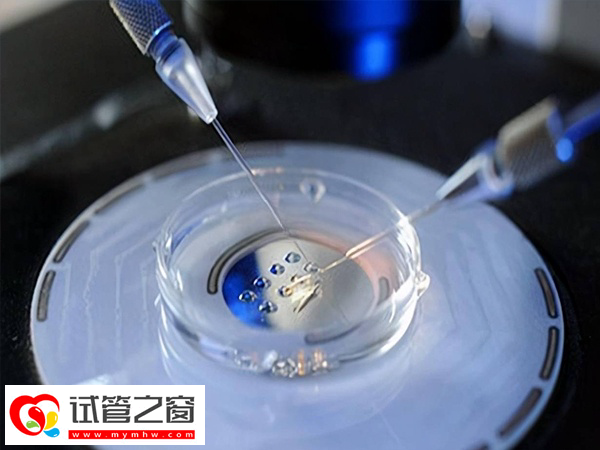
三代試管pgs篩查是什么意思(圖1) pgs篩查從技術上看可以選看性別

三代試管pgs篩查是什么意思
雖然三代試管嬰兒pgs篩查從技術上來說確實是可以看胎兒性別的,只是由于國家規定原因,在國內做三代試管嬰兒性別都是隨機的,并且本質上該項目是對疾病的排除,因此除非患者存在伴性遺傳病,才可以根據遺傳規律選擇胎兒性別。需要注意的是,除了版型遺傳病外,還可以對染色體異常、單基因遺傳病進行篩查。
三代試管pgs篩查是不是看性別
三代試管是在二代試管的基礎上進行23對染色體的篩查,同時也可以進行X/Y染色體的篩查,所以從技術的角度上來說是可以看性別的。但是由于我國遵循男女平等原則,未避免重男輕女思想,所以是禁止了任何非醫學需求的胎兒性別鑒定。

畢竟,第三代試管嬰兒pgs篩查技術指在IVF-ET的胚胎移植前,取胚胎的遺傳物質進行分析,診斷是否有異常,篩選健康胚胎移植,防止遺傳病傳遞的方法。
但在某些情況下,第三代試管pgs篩查可以進行性別篩查,在后代性染色體異常并帶來嚴重后果時允許性別選擇。具體來說,只有當一個女孩(或男孩)天生患有某種疾病時,才會允許性別選擇。詳情如下:
| 疾病種類 | 具體舉例 |
| x連鎖隱性遺傳病 | 如假肥大性肌營養不良(DMD)、色盲癥、睪丸女性化病、魚鱗蘚病、眼白化病I型、Hunter綜合征、無丙種球蛋白血癥I型、糖鞘脂貯積癥等 |
| X性連鎖顯性遺傳病 | 如抗維生素D佝僂病、口面指綜合征I型、高氨血癥I型、Alport綜合征、色素失調癥等。 |
| Y連鎖遺傳病 | 如遺傳性無精子癥:Y染色體AZFa、AZFb或AZFc區域缺失。 |
需要注意的是,第三代試管嬰兒技術選擇的是疾病,而不是性別,對于家族中有相關遺傳性疾病或者生育史的夫婦,在進行生育時可至遺傳科進行遺傳咨詢,必要時進行第三代試管嬰兒技術助孕。
2025第三代試管篩查哪些項目
三代試管嬰兒技術可以在胚胎移植到母體前,對胚胎進行遺傳學檢測,以篩查出攜帶特定遺傳疾病的胚胎,從而提高健康胚胎的移植成功率。這項技術主要針對染色體異常或攜帶遺傳疾病基因的夫婦,幫助他們生育健康的后代:
染色體異常
三代試管技術可以檢測胚胎的染色體結構和數目,從而分析胚胎是否存在染色體異常。染色體異常是導致遺傳性疾病的重要原因之一,如唐氏綜合征、羅氏易位等。通過PGD技術,可以選擇染色體正常的胚胎進行移植,降低染色體異常導致的遺傳風險。

單基因遺傳病
單基因遺傳病是由單個基因突變引起的遺傳性疾病,如地中海貧血、血友病、囊性纖維化等。三代試管技術可以檢測胚胎是否攜帶這些疾病的致病基因,從而篩選出健康的胚胎進行移植。





